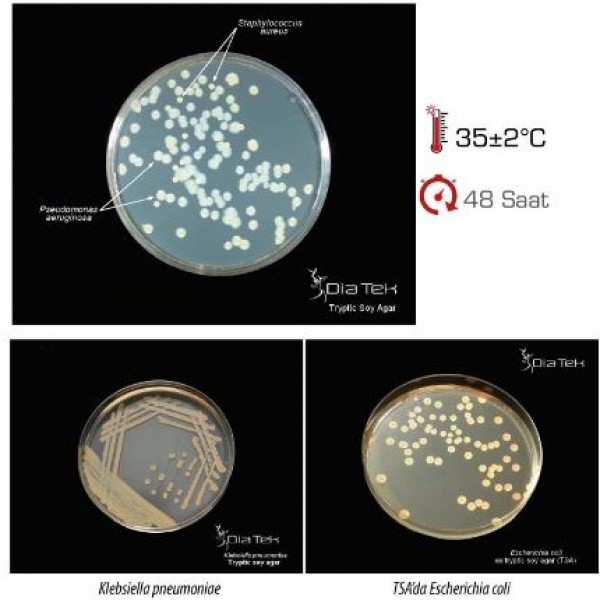

TSA Agar
TSA Agar
Tryptic Soy Agar çeşitli mikroorganizmaların gelişimi için kullanılan, genel amaçlı bir besiyeridir.
Bu besiyeri, toplam bakteri sayımı için kullanılır.
Ekimden sonra 35+-2 C’de , 24-72 saat inkübasyondan sonra oluşan tüm koloniler sayılarak analiz sonucuna gidilir.